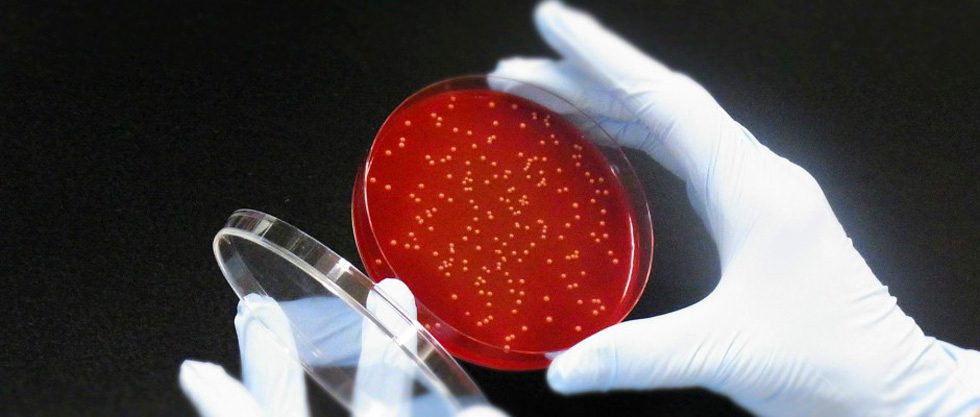
Japan’s Anaeropharma Science gets $13.1m led by European VC Seventure Partners

Register Now to Unlock Premium Content
Join top professionals who trust DealStreetAsia for their market insights.Get 2 free articles and 1 premium article each month
Get free access to Southeast Asia Startup Funding Report: H1 2025.
Receive curated newsletters straight to your inbox
Be the first to hear about upcoming events and summits
Register now - it only takes a minute! Log in if you already a reader.